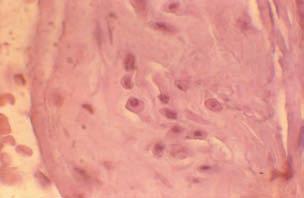

Obecná část
V zájmu hlubšího porozumění možnostem chirurgické a intervenční léčby cévních onemocnění je nutné si připomenout základní anatomicko-patologické, fyziologické a patofyziologické poznatky, které v podstatě určují hranice uvedených léčebných možností. Jejich respektování je nezbytným předpokladem správné diagnostiky, indikace, taktiky i techniky výkonu.
1.1 Poznámky anatomicko-patologické
Čistě obecně je vznik cévního systému spojen s počátkem vzniku vnitřního prostředí organizmu. Bylo by neúčelné zacházet do embryologických podrobností, ale výsledkem vývoje u teplokrevných organizmů je soustava distribuující krev jako prostředníka metabolizmu do všech tělesných tkání. Energií dodanou srdcem je krev vháněna do vysokotlakého systému tepenného a přes soustavu drobných cév přechází do nízkotlakého systému žilního. Tyto funkční nároky jsou pak základem anatomického uspořádání struktur, které umožňují tyto nároky naplnit. Tím je dána i stavba tzv. „velkého oběhu“. Kromě toho existuje i „oběh malý“, který prochází pouze plícemi a řadou vlastností se od oběhu velkého liší. Dále se budeme zabývat pouze systémem velkého oběhu.
Z levé komory srdeční vychází vzestupná aorta hrudní, která obloukem přechází v sestupnou část a na úrovni bránice se mění v aortu břišní zakončenou větvením společných tepen pánevních. Z aorty jako osové tepny odstupuje řada větví, které se dále větví až na úroveň tepének, které pak kapilárami přecházejí v žilky. Zatímco průměr vzestupné aorty je 26 – 30 mm, je u velkých tepen 8 – 10 mm a dále klesá v jejich větvích na 3 – 5 mm a u arteriol méně
než 0,6 mm až na hodnoty asi 0,009 mm u kapilár. Z jedné základní tepny však geometrickou řadou narůstá počet větví a větévek, takže když celkový průřez na začátku systému je kolem 5,5 cm2, pak u velkých tepen stoupá na 20 cm2, aby u arteriol již dosáhl 500 cm2 a u kapilár neuvěřitelných 3500 cm2.
Pro plnění funkce jednotlivých tepenných oddílů je klíčová jejich histologická stavba (obr. 1.1). Stěna tepen se v zásadě skládá ze tří vrstev – intimy, medie a adventicie. Vnitřní intima je kryta longitudinálně uspořádanými endoteliálními buňkami, pod nimiž je nevýrazná vrstva vazivových buněk a buněk hladké svaloviny (stratum subendoteliale). Na jedné straně je vhodné si uvědomit, že celková plocha endotelu činí asi 2000 m2 a svojí hmotností kolem 4 kg je bezkonkurenčně nejtěžší orgán v těle. Na straně druhé však endotel sám již za fyziologických podmínek představuje neuvěřitelně heterologní skupinu buněk (endotel arterií a vén) a za patologických poměrů je tato rozmanitost znásobena. Tunica intima je oddělena od tunica media vrstvou převážně elastické tkáně – membrana elastica interna. Střední vrstva –tunica media – je složena z desítek membrán představovaných elastickými fibrilami (u aorty) a mezi nimi je vmezeřeno pod úhlem 30 – 50° množství buněk hladkého svalstva a kolagenních vláken. Právě poměr elastinu, kolagenu a hladkých svalových buněk do značné míry charakterizuje typ tepny. Na zevní straně této medie je obvykle opět kondenzace vazivových elementů – membrana elastica externa, která odděluje medii od zevní vrstvy tepenné stěny – tunica adventitia – s ostrůvky tukové tkáně a bohatší či chudší sítí cévek – vasa vasorum – a nervů. Na základě histologické skladby jsou tepny rozděleny do tří skupin – tepny elastické, svalové a arterioly. V první skupině v medii převažují struktury elastického vazi-
33a21
4733b621
Obr. 1.1 Průřez tepenné stěny: a – tepna elastického typu (aorta), b – tepna svalového typu. 1 – endotel, 2 – intima, 3 – media (3a – membrana fenestrata, 3b – svazky hladkých svalových buněk), 4 – adventicia, 5 – vasa vasorum, 6 – membrana elastica interna, 7 – membrana elastica externa.
va nad buňkami svalovými. Typickým představitelem je aorta a její hlavní větve. Pružnost těchto tepen daná histologickou stavbou udržuje v průběhu diastoly tlak a průtok a současně mění pulzní proudění v proudění plynulé. Se zmenšováním průsvitu větví narůstá v medii podíl hladkých svalových buněk na úkor tkáně vazivového charakteru, například tepny brachiální, femorální a podobné velikosti. Tepny svalového typu se významně podílejí na hodnotě celkového pe-
riferního odporu. Nepominutelný vliv na tento odpor mají ovšem i prekapilární svěrače arteriol, které velmi aktivně ovlivňují podíl krve přicházející do jednotlivých kapilárních sítí v souvislosti s celkovým stavem organizmu. Jednovrstevné kapiláry jsou pak konečným prostředníkem látkové výměny.
Topografie
Anomálie a variace v tepenném systému nejsou ani v dospělosti nijak vzácné, ale z hlediska léčebného jsou obvykle irelevantní. Většina vrozených vad, jako je koarktace aorty, cévní prstence a podobně, je účelově řazena do vrozených vad srdečních, protože jejich korekce je předmětem zájmu dětských kardiochirurgů.
Víceméně ojediněle nacházíme netypické odstupy, zdvojené tepny či jiné drobnější odchylky, které však v cévní chirurgii nepřispívají ke zvýšenému počtu komplikací, protože jsou odhaleny kvalitním předoperačním zobrazovacím vyšetřením.
Dokonalá znalost topografické anatomie operované oblasti a přísně subadventiciální preparace tepny je bezpodmínečným předpokladem úspěšné rekonstrukce, protože ne zcela vzácnou příčinou pooperačních komplikací je poranění anatomických struktur uložených v blízkosti typicky uložené tepny při preparaci, a to jmenovitě nervů. Za zmínku stojí n. femoralis v souvislosti s preparací a. femoralis communis, dále brachiální plexus při resekci I. žebra pro TOS, větve n. ischiadicus při preparaci tepen infraingvinálních a podobně. Zcela typickou cévní rekonstrukcí zatíženou ne nevýznamným počtem komplikací z porušení nervových struktur je rekonstrukce a. carotis. Zde je řada nervů jak krčních, tak kaudálních mozkových, které mohou být poškozeny v průběhu preparace. Nejčastější příčinou poškození není anatomické přerušení, ale spíše zhmoždění buď naloženým nástrojem, nebo rozvěračem, o čemž svědčí i skutečnost, že většina těchto postižení se po kratší či delší době upraví. I tak ovšem mohou být závažná, například porucha polykání s nebezpečím aspirace u postižení n. glossopharyngeus, stejně jako je postižení jazyka při poškození n. hypoglossus.
Vlastní kapitolou jsou změněné anatomické poměry při reoperacích, o čemž bude podrobněji pojednáno v jednotlivých statích. Nicméně již nyní je nutno mít na paměti, že zvláště relativně volně uložené struktury, jako je například ureter, se při hojivých procesech, ať již per primam, nebo per secundam, mohou posunout do poměrně velké vzdálenosti a v samotném
místě reoperace mohou být nervy i žíly zcela jinde než obvykle.
Patologie
Pro volbu optimálního léčebného postupu je nutno mít i představu o patologicko-anatomickém podkladu stávajícího tepenného postižení. Zcela obecně postižení tohoto systému se může projevovat ve třech podobách:
– zúžením až uzávěrem ovlivňujícím krevní proud; – výdutí ovlivňující kvalitu i odolnost cévní stěny; – porušením cévní stěny postižené úrazem či onemocněním a projevující se buď disekcí, nebo přímo krvácením.
Je řada i závažných postižení tepenného systému, která se vyskytují i při zcela zdravé stěně tepny. Klasickým případem může být embolie, která, pokud se jedná o embolii do tepenného systému, má zdroj buď v srdci, nebo v jiném, degenerativně změněném úseku tepenného systému a náhle uzavírá do té doby zdravé řečiště většího či menšího průsvitu. Jiným případem může být útlak tepny ze zevnějšku, například nádorem či srůstem. Tyto případy, stejně jako poranění tepen, budou probrány v samostatných oddílech.
Zúžení a uzávěry průsvitu (stenosis, obliteratio)
Z chronických stavů, které ovšem nevylučují akutní projevy, je nejčastější příčinou onemocnění stěny tepny arteriosklerózou (dřívější snahy označovat výrazem ateroskleróza chorobu a výrazem arterioskleróza histologické změny stěny tepny se neujaly a oba dva výrazy jsou synonyma), která se vyskytuje jmenovitě u tepen elastického typu a postižením zvláště intimy vede ke tvrdnutí a ztluštění stěny tepny. U tepen muskulárního typu postihuje tento degenerativní proces hlavně medii a někdy je pro něj užíván výraz medioskleróza. U arteriol pak jsou postiženy buď intima nebo media, ale nejčastěji obě vrstvy a pro tento typ je rovněž užíván výraz arterioloskleróza.



Obr. 1.2 Příklad arteriosklerotického postižení tepny. Arterioskleróza stehenní tepny (a). Intima ztluštělá buňkami chudou tkání (50x) (b). V intimě jsou oxyfilní buňky s výskytem hladce svalových sarkolemálních vláken, v plazmatu aktin „metaplastické svalové buňky“ (500x) (c). Většina buněk ve ztluštělé intimě odpovídá směsi fibroblastů a makrofágů (250x) (A. Jirásek). a b c
V této práci se nehodláme zabývat přehršlí hypotéz a teorií o vzniku aterosklerózy. Důležité však je jakým způsobem je ovlivněna anatomicko-histologická struktura tepny, protože to má přímý dopad na volbu léčebného postupu (obr. 1.2). Arterioskleróza je charakterizována v počátečním stadiu infiltrací intimy lipidy, které jsou převážně zavzaty do makrofágů, ale rovněž i v prostupujících vazivových strukturách, které se rovněž podílejí na následném ztlušťování intimy. Dochází k postupnému usazování kalciových solí a cholesterolových esterů, což spolu s fibrotickou reakcí a pronikáním trombocytů vede ke vzniku
Chirurgická a intervenční léčba cévních onemocnění
typického ateromu, jehož konzistence závisí na poměru lipidů a kalciových solí. Zhoršující se perfuzní výživou degenerují vnitřní vrstvy medie, které jsou rovněž infiltrovány lipidy. U tepen elastického typu jsou změny poměrně ostře ohraničeny v zevní třetině medie, zřejmě díky tomu, že tato část je vyživována převážně z vasa vasorum adventicie. To má zvláštní význam při odstraňování ateromu při endarterektomii. V souvislosti s popsanými změnami dochází ztlušťováním intimy a nakonec i medie k zužování průsvitu tepny až k úplnému uzávěru.
Poslední stadium pak představuje trombóza zúženého úseku v důsledku depozit mechanicky rozbíjených trombocytů o nerovný povrch ateromu a proudovými změnami v místě zúžení.
Ne nevýznamným způsobem se účastní i elementy zdravé s aktivovanými receptory. Vzhledem k tomu, že postupující omezovaní průtoku hlavním kmenem dovoluje rozvinutí kolaterálního oběhu, neprojevuje se obvykle tato konečná fáze zvláště dramaticky. U muskulárních typů tepen je postižena primárně medie, a to projevy degenerace spojené s bobtnáním fibril a jejich fragmentací s následným usazováním kalciových depozit, a to v takové míře, že někdy připomínají na pohmat kost a histologicky můžeme mluvit o osifikaci. Změny medie samy o sobě neomezují průsvit tepny, ale při delším trvání trpí i intima a druhotně se zde usazují lipidy s následným ztluštěním. Tento charakter změn má ovšem vliv na možnosti i techniku endarterektomie.
Posuzování tíže arteriosklerózy bylo vždy problematické, o čemž svědčí i skutečnost, že to bylo též předmětem výzkumu WHO. Ve skutečnosti je arterioskleróza kombinací arteriosklerózy centrální (aortální) – koronární – končetinové – renální a cerebrální. Ty se mohou vzájemně kombinovat, jak vyplývá ze studie MONICA. Všechny typy přibývají s věkem nemocného. Kombinace jsou důkazem výrazného společného faktoru, ale jsou určité odlišnosti, například arterioskleróza koronární je výrazně trombogenní. Patologové rozdělili arteriosklerózu do tří skupin: Gr. I je vyhrazen pro lipidní skvrny až pláty, Gr. II pro pláty až ulcerace a Gr. III pro pláty s ulcerací a trombózou. Všeobecně však platí, že u stejného jedince patologové hodnotí nález jako daleko těžší než vyplývá ze studie klinické na základě subtrakční analýzy radiodiagnostického nálezu.
Změny, které postihují arterioly pod shrnujícím pojmem arterioloskleróza, jsou charakterizovány hyalinizací a proliferací intimy a hypertrofií a degenerací medie. Je obvykle v určité oblasti generalizovaná a pokud postihuje tepny ledvin, může vést
k hypertenzi. Chirurgické možnosti u tohoto typu postižení jsou krajně limitovány.
Kromě těchto nejčastějších onemocnění shrnutých pod názvem degenerativní je možno diagnostikovat i choroby jiného typu, celkem nepřesně označovaná jako zánětlivá. Mají odlišný průběh a léčbu, často jsou sdružena s jinou nemocí, jako třeba diabetem, a jsou zcela nevhodná k přímé chirurgické léčbě. Zvláště mezi ně patří:
– Endarteriitis obliterans: je charakterizována tím, že lokalizovaně postihuje malé tepny, které se uzavírají následkem zmnožování vazivových struktur vyrůstajících z vnitřní elastické lamely mezi intimou a medií. Patrné zvláště v okolí proběhlých zánětlivých procesů.
– Thromboangoitis obliterans (m. Winiwarter-Buerger): je to chronické obliterující onemocnění postihující převážně tepny a žíly dolních končetin, kde jsou patrné prchavé a migrující, mikrobiologicky negativní záněty, které se hojí za cenu obliterace příslušné cévy, což významně ovlivňuje krevní zásobení končetiny. Stav se hojí výraznou reakcí fibrotického charakteru, která často váže tepnu, žílu i nerv v jeden jizevnatý celek.
– Polyarteriitis nodosa: onemocnění postihující střední a malé tepny a projevující se nejdříve nekrotickými změnami v medii, v další fázi pak celulární exsudací s významnou přítomností eozinofilů a následnou proliferací granulační a vazivové tkáně. Současně lze nalézt všechna stadia onemocnění. Často se objevuje v případech alergií na nejrůznější podněty.
– Fibromuskulární dysplazie: je charakterizována abnormálním výskytem a růstem vazivové tkáně ve stěně tepny, zpravidla v podobě korálků, ale to je jen jeden typ. Vyskytuje se obvykle v renálních tepnách mladších žen.
Výduť pravá (aneurysma verum)
Je místní rozšíření průsvitu tepny. Má zachovány všechny typické vrstvy, i když často těžce patologicky změněné. Po stránce tvaru jsou fuziformní a sakulární. Mohou postihnout kteroukoliv tepnu, ale nejčastěji se vyskytují v oblasti subrenálního úseku břišní aorty. Dynamika rozvoje výdutě je problémem patofyziologickým a bude probrána v příslušné stati. Stav může být zhoršen, pokud dojde k prasknutí ateromu a tlak působí přímo na nemocnou medii. Příčina onemocnění je nejčastěji:
– Arterioskleróza – klasicky postihuje intimu a později medii, která zvláště u elastických tepen je poměrně citlivá na výživu a zvýšený laterální tlak degeneraci urychluje. Typická je výduť fuziformní.
– Zánětlivá – typická je výduť mykotická, což je název povýtce historický a s mykózou nemá nic společného; původní Oslerův termín se vztahoval k houbovitému tvaru. Vyskytuje se převážně v oblasti břišní aorty. Infekce je zanesena buď přímo krevním oběhem a zachycením na trombu, nebo cestou vasa vasorum. Histologický obraz je typický pro nespecifický hnisavý bakteriální zánět s rozpuštěním jednotlivých vrstev stěny, a proto v pozdějším vývojovém stadiu bývá oprávněně zařazená mezi výdutě nepravé.
Disekce
Je charakterizována proniknutím cirkulující krve do stěny tepny trhlinou v intimě a části medie. Tlak krve roztlačuje vrstvy do různé vzdálenosti. Toto falešné lumen nikdy nezaujímá celý obvod tepny. Na periferii se někdy trhá směrem do průsvitu, méně často vně a někdy končí slepě. Vyskytuje se většinou v oblasti hrudní aorty. Patologickým základem bývá cystická medionekróza. Typická je tuková degenerace a atrofie buněk hladkého svalstva a hyalinní a mukoidní degenerace vazivové tkáně, kde jsou mezi elastickými vlákny pozorovatelné drobné cysty.
Poměrně často se stále používá výraz disekující výduť (aneurysma dissecans). Tento chybný a zavádějící termín by se dávno neměl používat, protože je pramenem obvyklého směšování ruptur výdutí a akutních disekcí!
Výduť nepravá (aneurysma falsum)
Je tvarově a strukturálně charakterizovaná tím, že je sakulární a stěna výdutě není tvořena vrstvami tepenné stěny, ale fibrotickou tkání opouzdřeného hematomu, protože původ je obvykle traumatický, nezřídka iatrogenní. Nicméně i aterosklerotické či mykotické výdutě mohou být svým charakterem nepravé, u mykotické je to při dalším vývoji naopak typické.
i časovým průběhem rozdílné. Od toho se odvíjejí i klinické důsledky.
Při náhlém vzniku je nejčastější příčinou ostré poranění, a to buď primární původcem zranění, či sekundární ostrým úlomkem jiné anatomické struktury. Při pozvolném vzniku dochází k porušení tepenné stěny patologickým procesem v bezprostředním okolí. Samostatnou kapitolu pak představují prasklé výdutě, kde celý mechanizmus je specifický.
1.2 Poznámky fyziologické
Úkolem cévního systému je zásobování všech orgánů těla krví, a to za všech okolností, od klidového stavu po námahové zatížení. Fyzikálně ho můžeme pokládat za uzavřený systém trubic s centrálním bodem, kterým je srdce. Jedná se vlastně o dva sériově zapojené systémy. Malý oběh: srdce – plíce – srdce a velký oběh: srdce – orgány – srdce, při čemž tento velký oběh je představován soustavou paralelních okruhů, jejichž vzájemný vztah se mění v souvislosti s momentálním zatížením organizmu. Úmyslně pomineme paralelní systém lymfatický, který sbírá přebytek intersticiální tekutiny a vrací zpět do venózního systému, protože je řízen jinými mechanizmy.
Tepenná soustava velkého oběhu zajišťuje přítok okysličené krve orgánům, při čemž nepomíjíme distribuci ostatních životně důležitých působků a význam pro termoregulaci.
Potřebnou energii pro tuto činnost dodává srdce, v tomto případě levá srdeční komora, která každým tepem vypudí do oběhu přibližně 70 ml krve pod tlakem 16 kPa (120 mm Hg).
Minutový srdeční výdej je přibližně kolem 5 litrů. Při srdeční diastole pak tlak v tepenném systému ve velkých cévách klesá v průměru na 10,7 kPa (80 mm Hg). Přitom si musíme uvědomit, že z celkového objemu krve kolem 5 litrů (6 – 8 % tělesné hmotnosti) je v tepnách pouze 20 %, protože 80 % se nachází v systému nízkotlakém (žíly, pravé srdce, malý oběh).
Porušení stěny
Již samotný charakter tohoto postižení napovídá, že příčiny mohou být značně různorodé a topograficky
I když se nabízí mechanistické srovnání s chováním dokonalých kapalin v soustavě tuhých trubic s čerpadlem, bylo by to krajně scestné, protože situace je mnohem komplikovanější a člověk dosud nevytvořil zařízení srovnatelně dokonalé. V první řadě je cévní systém naplněn tak složitým médiem jako je krev složená z plazmy (55 %) a krevních elementů. Jedná se tedy o neideální viskózní tekutinu, spíše suspenzi, při čemž viskozita se může v dosti širokém rozsahu i časovém rozmezí měnit. Krevní
Chirurgická a intervenční léčba cévních onemocnění
průtok musí zajistit minimální prokrvení všech tkání se současnou preferencí orgánů momentálně intenzivněji pracujících a současně se významně podílet na zajištění účinné termoregulace.
Pohyb krve je v principu určován energií dodanou stahem srdce a periferní rezistencí, i když svou úlohu hraje elasticita velkých tepen a viskozita krve. Krev zásadně protéká po tlakovém spádu. Pro zásobování orgánů je klíčový průtok krve za minutu. Ten je ovlivněn v první řadě tepovou frekvencí srdce a sílou stahu a obě tyto hodnoty jsou řízeny především sympatikem a parasympatikem. Na druhé straně je prokrvení orgánů, a druhotně periferní odpor, ovlivněno především změnami průsvitu cév. Na tonus jejich svaloviny působí jednak vlivy místní, jednak podněty nervové či humorální. Když k tomu připočteme významný vliv vazomotorického centra v prodloužené míše, které je protkáno aferentními vlákny z kůry mozkové, hypotalamu, chemoreceptorů, baroreceptorů, a řady jiných zdrojů, pak teprve nabývá problematika regulace krevního oběhu obrysů celé své složitosti.
Optimální průtok krve je v zásadě ovlivněn několika faktory, z nichž nejdůležitější jsou:
– Tlak, lépe řečeno tlakový rozdíl mezi dvěma body trubice, za kterou zjednodušeně můžeme pokládat tepnu. Úměrně se stoupajícím tlakovým rozdílem stoupá rychlost krevního proudu.
– Rychlost krevního proudu, která je nepřímo úměrná průřezu tepny v místě měření. Proto průměrná rychlost, pokud bereme systém jako celek, je relativně největší v aortě a nejmenší v kapilárách, jejichž celkový průřez je 1000x větší. Na rychlosti proudu pak závisí jeho charakteristiky.
– Charakter proudu za optimálních okolností je laminární. To znamená, že elementy postupují souběžně, ale různou rychlostí, od minimální při stěnách tepny až po maximální ve středu trubice. Proud zůstává laminární až do určité kritické rychlosti, při níž se mění ve vířivý proud turbulentní. Tento vztah vyjadřuje Reynoldsovo číslo odvozené ze vztahu:
q · DV
R = ––––––n
kde q = hustota kapaliny, D = průměr trubice, V = rychlost a n = viskozita. Čím vyšší je Reynoldsovo číslo, tím větší je sklon k turbulenci. Za kritickou hodnotu Reynoldsova čísla se pokládá 2300.
Víření lze někdy za fyziologických poměrů pozorovat na ascendentní aortě, ale nabývá to na význa-
mu hlavně za podmínek patologických. Je důležité si uvědomit, že zatímco laminární proud je tichý, turbulence je provázena šelestem.
– Průsvit tepny hraje rovněž svoji roli v krevním průtoku, protože ten se mění přímo úměrně se čtvrtou mocninou průměru, zatímco odpor se mění nepřímo úměrně. Proto i malé změny v průsvitu tepen mohou mít výrazný vliv na průtok.
– Pružnost stěny tepny, zvláště pak velké, se významně podílí na změně proudu pulzatilního v kontinuální. Pokud hovoříme o aortě, pak střední rychlost je asi 40 cm/sec, ale v systole je téměř 120 cm/sec a až k negativním hodnotám klesá v diastole. Při tom se průřez zvětší asi o 22 %. Z hlediska celého tepenného systému elasticita stěny rovněž umožňuje působení Laplaceova zákona, který dokazuje, že čím větší je poloměr tepny, tím větší je napětí ve stěně a vice versa. Normální elasticita tepenné stěny je rovněž důležitým předpokladem časového postupu pulzové vlny a je známo, že pro perfuzi při nejmenším některých orgánů je, z důvodů zatím ne zcela jasných, pulzatilní proud důležitý.
– Kvalita povrchu tepny hraje důležitou roli hlavně při patologických procesech. Při této příležitosti je nutno se zmínit o významu tzv. smykového (tečného) napětí (shear stress). To vyjadřuje jednak tření mezi jednotlivými vrstvami proudící tekutiny a jednak tření mezi tekutinou a stěnou trubice. Jeho význam pro kvalitu krevního proudu a nakonec i pro rozvoj patologických změn stěny tepny řeší řada teorií, ale je nepochybné, že hladká vrstva endotelu je pro hodnotu smykového napětí optimální.
– Reologické vlastnosti krve do značné míry ovlivňují krevní proudění, a to tím více, čím je předmětná tepna menšího průsvitu (obr. 1.3). Krev jako ne-newtonská tekutina je vlastně suspenzí nejrůznějších složek a její základní vlastnost – viskozita – závisí na vztahu smykového napětí (shear stress) a smykové rychlosti (shear velocity) a tento vztah je vyjádřen Newtonovým zákonem viskozity. Při vysoké rychlosti, například v aortě, hodnota viskozity klesá až k hodnotám blízkým newtonské tekutině a naopak. (U newtonské kapaliny s růstem smykové rychlosti roste odpor lineárně, u kapaliny ne-newtonské tomu tak není – obr. 1.4).
Z tohoto stručného přehledu některých základních fyziologických údajů vyplývá, že zásahy do tohoto velmi delikátního systému musí brát v potaz možnosti nepříznivého ovlivnění a respektovat v maximální možné míře známé zákonitosti. Ovšem díky vysoké
Rozložení pole rychlosti
Rozložení pole tečného napětí
Rozložení Reynoldsova napětí
Průtok Q = 250 ml/min
Rozložení intenzity turbulence
Obr. 1.3 Fyzikální parametry proudění (J. Adamec, J. Matěcha – ČVÚT).
adaptabilitě organizmu je tento schopen se vyrovnávat i se situacemi, které rámec fyziologických zákonů přesahují.
Je nutno si také uvědomit, že fyziologické charakteristiky krevního oběhu staví určité mantinely i pro konstrukci některých implantabilních i neimplantabilních prostředků a zařízení použitelných v cévní rekonstrukci jako jsou cévní náhrady, stenty, pomocná zařízení asistující krevnímu oběhu a podobně.
1.3 Poznámky patofyziologické
Řada patologických procesů ovlivňuje tepenný systém buď nepřímo, nebo přímo. I když první skupina je velmi rozsáhlá a dotýká se prakticky všech medicínských oblastí, vzhledem k charakteru práce se zaměříme pouze na přímé postižení cévního, v daném případě tepenného, řečiště.
Zúžení a uzávěry
Zúžení, neboli častěji používaný výraz stenóza, je typickým projevem degenerativního onemocnění tepenné stěny, zvláště pak arteriosklerózou. Projevuje se dvěma způsoby. Jednak zužuje účinný průsvit postižené tepny, jednak mění kvalitu stěny, mnohdy až bizarním způsobem, což má pochopitelně vliv na proudící krev.
Vliv stupně stenózy lze odvodit z Poiseuilleova zákona, který vyjadřuje vztah mezi viskozitou, průtokem tenkou trubicí a poloměrem této trubice. Matematické závěry byly opakovaně empiricky ověřeny a ukazuje se, že výraznější vliv na průtok mají stenózy, jejichž průřez je zmenšen patologickým procesem nejméně o 70 %, při čemž délka stenózy
Obr. 1.4 Rychlostní profily newtonské a ne-newtonské tekutiny (J. Konfršt – Ústav hydrodynamiky).
Porovnání rychlostních profilů z pohledu newtonské a ne-newtonské kapaliny ve stejném místě měření; Re = 500; při dvou fázích cyklu (180° a 350°); frekvence 60 Hz; model Dint = 6 mm.
nehraje významnější úlohu. Na druhou stranu, pokud za sebou následuje řada i krátkých stenóz, pak se již hemodynamicky projevují. To je ovšem hledisko klinické s ohledem na prokrvení zásobovaného orgánu v klidovém stavu. Neznamená to, že i méně výrazná zúžení charakteristiky krevního proudu výrazněji neovlivňují. Naopak, s narůstajícím zúžením při zachování žádoucího průtoku stoupá tlakový gradient a tím i smyková rychlost, která je největší na konci stenózy (viz obr. 1.3). Tryskový efekt v rozšířené části tepny vede k rozpadu laminárního proud v turbulentní, zvláště u stěn tepny, kde může mít až obrácený směr (obr. 1.5). Při delším časovém působení je intima cévy postupně mechanicky narušována se všemi důsledky. Je nutno si uvědomit, že při neměnné periferní rezistenci se vzrůstajícím přívodným tlakem stoupá i tlakový gradient, a tedy i rychlost proudu, a klesá tedy hodnota kritičnosti stenózy. Tím lze vysvětlit, že prokázané, v klidu klinicky němé stenózy se hemodynamicky projeví při zvýšené aktivitě zásobovaného orgánu, což je typické pro svaly dolních končetin. Četnými zobrazovacími metodami je možno téměř přesně určit stupeň zúžení, ale bylo by chybou hodnotit jeho význam pouze z momentálního klinického hlediska dostatečného prokrvení zásobovaného orgánu.

Vzhledem k tomu, že onemocnění tepenné stěny je primární příčinou vzniku zúžení a charakter proudění je ze shora uvedených důvodů nadále narušován i za stenózou, je nutné se zabývat otázkou, do jaké míry může samotná kvalita stěny ovlivnit krevní průtok. Pokud je arterioskleróza typu hladkého zbytňování intimy ukládáním lipidů a jiných látek a zůstává hladká i bez krytu endotelem, nemá sama o sobě zásadnější význam. Situace se však mění, když v dalším průběhu se na narušenou intimu začínají zachycovat trombocyty a jiné elementy. V tomto případě hrozí dvojí nebezpečí. Jednak tyto houbovité drsné útvary mohou vyprovokovat koagulaci s následným uzávěrem, nebo se mohou udrolit a embolizovat periferii do úrovně svých rozměrů. Vzhledem k minimální velikosti to u periferních tepen jednorázově nemá valný vliv, ale situace se může zkomplikovat při opakované embolizaci.
To vše nasvědčuje tomu, že z patofyziologického hlediska každá stenóza představuje potenciálně závažné narušení normálních poměrů krevního průtoku a musí být proto velmi zodpovědně hodnocena, a to nejen podle lokality stenózy, ale i podle důsledků předpokládané progrese, protože je obecná zkušenost, že i když stenóza může přetrvávat dlouhou dobu, tak existuje vysoká pravděpodobnost, že dříve či později skončí uzávěrem, i když zatím nikdo neprokázal, že je to všeobecné pravidlo v časovém horizontu daném lidským životem.
Uzávěr představuje kvalitativně zcela odlišné ovlivnění průtokových poměrů než stenóza. Na rozdíl od stenózy, která má vždy pozvolný charakter (pokud
pomineme artificiální zúžení převážně iatrogenního původu), má uzávěr dvě podoby vzniku – akutní a chronický. Jejich patofyziologické důsledky se také zásadně liší.
Akutní tepenný uzávěr je většinou způsoben embolií, která zpravidla vychází ze srdce, ať již levé síně při fibrilaci nebo komory při ischemickém ložisku, a je představován hmotami vyzrálého trombu. Masivnější emboly tohoto typu se většinou zastaví na větvení buď aorty, nebo velkých kmenů. Typický je sedlovitý embolus uvíznuvší na větvení břišní aorty. Menší pak pronikají dle své velikosti do větvení tepen prakticky kdekoliv, ale existují predilekční místa, jako je povodí a. carotis, tepny horních a dolních končetin, ale i a. mesenterica superior či tepny renální. Klinický obraz je pak dán postiženou oblastí. Při uzávěru tepny vmetkem se situace zhoršuje téměř okamžitým periferním tepenným spazmem, který bez léčby trvá 6 – 8 hodin. Okamžitá zástava krevního průtoku zakládá optimální podmínky pro sekundární trombózu periferně od uzávěru, která postupně postihuje větve na všech úrovních až do kapilár. Rychlost vzniku této sekundární trombózy závisí jednak na hematologickém stavu, ale také na stavu tepen periferně od uzávěru či užívání některých farmakologicky účinných látek. V průměru trvá její rozvoj 6 až 12 hodin, ale obecně lze říci, že čím kratší uplyne doba od embolizace do obnovení krevního průtoku, tím je naděje na restituci ad integrum větší. Jedná se totiž o kritickou komplikaci, které musí zabránit účinná antikoagulační léčba při prvním lékařském ošetření, protože jakmile se rozvine, jsou veškeré další léčebné pokusy
Obr. 1.5 Vliv stenózy na proud (H. Netřebská – ČVÚT).
Chirurgická a intervenční léčba cévních onemocnění
buď zcela neúčinné, nebo při nejlepším značně zkomplikované. Dochází totiž k řetězovitému rozvoji přes kapiláry na žilní řečiště s následnou odúmrtí tkání. Bezprostřední důsledky jsou v přímé návaznosti na postižený orgán. Nejkratší životnost mají buňky mozkové, které jsou již po několika minutách nevratně zničeny. Velmi citlivé jsou rovněž ledviny a myokard, stejně tak jako střevní endotelie. Nejčastěji bývá náhlým uzávěrem postižena některá tepna periferní a svalová tkáň, která odolává ischemii řádově v hodinách, maximálně však do 24 hodin. Ze všech tkání nejméně citlivá na přerušení krevního proudu je kůže a podkoží. Situaci však nelze chápat tak zjednodušeně, že se jedná o pouhý nedostatek kyslíku. V tkáni se hromadí kyselé zplodiny látkové výměny, což důsledky ischemie dále prohlubuje.
I když tromboembolické hmoty jsou nejčastějším původcem embolie, nelze pominout ani vmetky jiného původu. V tepenném řečišti se jedná obvykle o odtržené hmoty z degenerativně změněných cév, nebo odtrženou vnitřní výstelku nedokonale vhojené, dříve implantované cévní protézy. Rovněž ne zcela vzácné jsou příčiny iatrogenní, nejčastěji odlomený kousek intervenční cévky nebo embolie vzduchová. Ta ovšem má zcela jiný mechanizmus účinku. Celý krevní oběh je založen na nestlačitelnosti tekutiny, konkrétně řečeno krve. Vzduch je však stlačitelný a jakmile se dostane do tepenného oběhu, jednak se vymkne fyzikálním předpokladům pohybu krve v systému a jednak má tendenci postupovat antigravitačně sám o sobě. Proto vzduchová embolie v tepnách nejčastěji postihuje větve tepen zásobujících mozek. Množství vzduchu, které se v tepenném systému škodlivě uplatní v tom či onom rozsahu, je individuální od 5 do 30 ml a výše.
Časový odstup obnovení krevního průtoku je kritický i pro rozvoj dalších patofyziologických mechanizmů, které se přímo odvíjejí od charakteru postiženého orgánu a jeho hmotnosti a svým průběhem mohou ohrozit organizmus jako celek. I v těchto případech nelze pokládat časový odstup za dogma s ohledem na vysoce individuální reakci postiženého orgánu na náhlé přerušení oběhu. Klasickým příkladem může být mozek, který svým charakterem je pro přežití organizmu klíčový. Rozhodující je nález neurologický. Na jedné straně náhlý uzávěr obvykle vyvolá malacii vždy spojenou s nevratným poškozením postižených buněk a obnovení krevního proudu v tomto stadiu je kontraproduktivní, protože by vyvolalo krvácení do malatického ložiska a další rozšíření poškození. Na druhé straně individuální možnosti kolaterálního oběhu mohou prodloužit životnost postižené oblasti na řadu hodin, během které obnovení průtoku podstatně zvyšuje naději na minimalizaci škod po proběhlé centrální mozkové příhodě. Náhlý uzávěr tepny ledvinné proběhne obvykle bez závažnějších klinických příznaků, někdy pouze přechodná tupá bolest v bedrech. Následný „bledý“ infarkt zničí během několika hodin postižené buňky, ale vzhledem k velké rezervní kapacitě ledvin neovlivní jednostranné postižení homeostázu. Nejobvyklejší je ovšem postižení objemné svalové hmoty při embolizaci do hlavních přívodných tepen dolních končetin. Patofyziologické důsledky náhlé ischemie vedou k acidóze, poškození buněčných membrán a zániku funkce sodíkové a draslíkové pumpy, což má za následek kromě jiného nasávání vody do buněk a rovněž uvolňování enzymů, které jsou zcela neškodné, pokud jsou uvnitř buňky, do okolí. Vzhledem k uzavření svalových skupin v pevných fasciálních prostorách stoupá intersticiální tlak z ± 4 mm Hg a při hodnotách nad 40 mm Hg dochází již k těžkému poškození tkání. Vzhledem k tomu, že kapilární průtok je závislý na tlakovém gradientu kapiláry – véna, který je normálně mezi 17 a 40 mm Hg a je ovlivňován zvýšeným venózním tlakem, sníženým přítokem, vazospazmem a zvýšenou permeabilitou kapilár, dochází poměrně velmi brzo k ireverzibilnímu poškození. Když není tlak uvolněn včas, je výsledkem vždy nekróza tkání v různém rozsahu a ta v lepším případě končí jako Volkmannova kontraktura. Pokud je fasciotomie provedena opožděně, pak při současném obnovení krevního průtoku se vyplaví z poškozených tkání kyselé metabolity, bílkoviny z poškozených myofibril a toxické superoxidační volné kyslíkové radikály. Čím náhlejší je obnovení průtoku, tím větší objem těchto látek je naráz vyplaven do organizmu a tím závažnější jsou celkové následky, zvláště pro plíce („šoková plíce“) a ledviny, kde při současné oligurii a hypotenzi dochází k precipitaci myoglobinu a selhání funkce ledvin. Tento stav se nazývá myonefropatický syndrom a je důsledkem „reperfuzního poškození“. Při správném léčebném postupu by k němu nemělo nikdy dojít. Je to jen další důkaz toho, že i menší opominutí může nastartovat patofyziologické pochody, které lze pak zastavit jen krajně obtížně.
Postupný tepenný uzávěr má zcela odlišný patofyziologický průběh, i když vlastně výraz postupný uzávěr je ošidný, protože nakonec každý uzávěr je náhlý, ale vyjadřuje se tím spíš stav tepenného řečiště v době uzávěru. Samotný uzávěr je dovršením obvykle degenerativních procesů stěny tepny, které se napřed projevují zúžením s důsledky, o kterých
již bylo hovořeno. Proces zužování zpravidla probíhá dlouhou dobu, měsíce až léta, a kompenzační schopnosti organizmu stačí vybudovat tam, kde to anatomické uspořádání dovoluje, více či méně vydatný kolaterální oběh. V oblastech, kde zvýšená činnost není spojena se zvýšenými energetickými nároky, jako je například mozek, to dlouho může unikat pozornosti. Zato v oblastech jiných, zvláště končetin, kde při zvýšené námaze nároky na krevní přítok několikanásobně stoupají, již kolaterální oběh nestačí tyto nároky uspokojit a dochází k projevům ischemie. Účinnost kolaterálního oběhu je také do značné míry ovlivněna periferní rezistencí a maximální snížení této veličiny tím či oním způsobem je žádoucím ovlivněním patofyziologických mechanizmů v tomto případě.
Pochopení základních patofyziologických skutečností je důležitým předpokladem stanovení správné diagnózy – náhlý uzávěr zapříčiněný embolií nebo konečná fáze chronického zúžení – již klinickým vyšetřením. Ovšem kromě orgánů nitrobřišních a také pochopitelně i u větví zásobujících mozek, kde přinejmenším sonografie je indikována vždy. To má svou důležitost, protože u embolie je předoperační angiografie zbytečná, ale je žádoucí peroperačně. V druhém případě je však angiografie či jiná zobrazovací metoda nezbytným předpokladem správného postupu, protože je nutno plánovat rekonstrukci klasickou indikací. A také časový tlak v tomto případě není klíčovým momentem.
Výdutě
Kromě oblasti vzestupné hrudní aorty je nejčastější příčinou výdutí arterioskleróza. Není zcela jasné, proč se toto onemocnění objeví jednou v podobě obliterující a podruhé v podobě dilatující, při čemž oba typy mohou být, a bývají, i u jednoho organizmu. Důvodem je zřejmě specifická kombinace histologického profilu stěny tepny v daném místě a podmínek hemodynamických. Některé skutečnosti je možno demonstrovat na příkladu břišní aorty. Všechny tepny, a aorta zvláště, jsou v těle uloženy a priori pod určitým napětím. Po vyjmutí z těla se elastická tepna zkrátí přibližně o 30 % (zatímco tepna svalového typu až o 60 %).
Tato charakteristika je nepřímo závislá na věku nositele. U starších osob tato hodnota klesá na 15% zkrácení. S tím souvisí i podélná a příčná pružnost, kdy z 80 %, resp. 30 %, klesá po šedesátce na 40 %,
resp. 15 %. Elasticita stěny klesá asi o 30 %, ale síla nutná k porušení kontinuity stěny vnitřním přetlakem jen asi o 10 %.
Vznik a rozvoj výdutě se opírá o jednoduchý fyzikální princip vyjádřeny Laplaceovým zákonem T = Pt · r, kdy T je napětí stěn, Pt je transmurální tlak (intraluminální tlak minus tlak ze zevnějšku) a r je vnitřní poloměr. Při tom vstupují do hry dříve zmíněné faktory, jako je tloušťka a kvalita stěny a věk postiženého, který se rovněž uplatňuje při pozorované postupné redukci vasa vasorum zvláště ve velkých tepnách. Jednoduchou aplikací zmíněného zákona dojdeme k závěru, že čím větší je průsvit postižené tepny, tím větší je laterální tlak i rychlost růstu výdutě. Často přítomná hypertenze zvětšuje tlakový gradient, a tím také zvyšuje krevní průtok a navazující tryskový efekt a bludný kruh se uzavírá.
Můžeme si představit dva teoretické modely vzniku arteriosklerotické výdutě. V jednom případě na určitém místě vznikne sklerotický plát, který i nepatrně zužuje tepnu v daném místě, a tím dochází k relativnímu nepoměru průsvitu, a rozvinou se mechanizmy dle uvedeného zákona. Pochopitelně čím větší je postižená tepna, tím se působící síly násobí. Druhý model pak představuje situace, kdy z důvodů snížení metabolického zásobení určitého úseku stěny dojde k jejímu zeslabení a příčné síly se uplatní do té míry, že opět vytvoří relativní nepoměr průsvitů. K tomu všemu přispívá „tryskový efekt“ již dříve popsaný. Ovšem možných příčin je daleko více, není to čistě mechanická záležitost.
Další průběh vyplývá z předcházejícího a nabízejí se tři možnosti. Jednak je to spontánní trombóza výdutě, ale tu pozorujeme výhradně na tepnách končetinových, vzácněji na tepnách v povodí a. iliaca interna. Další možností je pokrytí vnitřního povrchu i velmi silnou vrstvou trombocytárních hmot obohacených o četné jiné krevní elementy a v různé etapě zralosti. Tato vrstva postupně narůstá a zbytkový průsvit se nemusí výrazněji lišit od normálního průsvitu tepny v daném místě či být i menší. To ovšem představuje trvalý zdroj možných menších či větších embolizací do periferie, protože soudržnost těchto hmot je přinejmenším diskutabilní. Na druhou stranu snižuje tato vrstva podle tloušťky laterální tlak až o 50 %, jak bylo prokázáno počítačovou simulací, a tím zpomaluje narůstání výdutě.
Nejčastější komplikací je prasknutí výdutě a v současnosti se za kardinální známku předpokládané prognózy pokládá velikost výdutě v době zjištění. Pokud sám o sobě je tepenný systém jako celek mohutnější než je obvyklé (nad 50 % tzv. arteriomegalie), je ri-
Chirurgická a intervenční léčba cévních onemocnění
ziko úměrně větší. Vlastní mechanizmus je různý dle lokalizace výdutě.
Někdy uniká pozornosti, že stejné fyzikální zákony a patofyziologické mechanizmy ovlivňují i tepenné rekonstrukce, ať již provedené jakýmkoliv způsobem. Proto musí být velmi pečlivě zvážen průsvit použité náhrady v každém individuálním případě, ale problémy může způsobit i nadměrná intraarteriální dilatace, když léčenou stenózu převede v dilataci.
Disekce podléhají v zásadě stejným fyzikálním a biologickým zákonům, ale za podmínek pro organizmus daleko horších, protože po vytvoření falešného lumina stojí v cestě mohutnému krevnímu tlaku pouze zbytek medie a adventicie. Terapeuticky logická interpretace působících vlivů pak nutně vyústí v nezbytnost podstatného snížení krevního tlaku s cílem získání času. Ovšem kromě bezprostředního rizika masivního krvácení vede separace stěny i k nebezpečí odtržení intimy a části medie důležitých větví, jak bude pojednáno v příslušné kapitole.
1.4 Diagnostika
1.4.1 Vyšetření klinické
Jako v kterémkoliv jiném medicínském oboru je i v péči o nemocné s chorobami cév základem správné diagnózy a léčby pečlivé vyšetření nemocného prostředky, které jsou v té či oné chvíli k dispozici. I když u většiny nejčastějších onemocnění tepen (a nakonec i žil) je možno učinit správnou diagnózu již na základě vyšetření klinického, tak pro odpovědné stanovení optimálního léčebného postupu je třeba využít ze škály dnes dostupných ty, které nám zajistí dostatečné množství informací pro nejlepší možné řešení.
Z řečeného vyplývá, že komplexní vyšetření je vlastně etapové podle reálných možností toho či onoho pracoviště. Praktický lékař může již klasickým vyšetřením odfiltrovat nemocné, jejichž příznaky ani nález nesvědčí pro cévní onemocnění. V další etapě odborný lékař s většími vyšetřovacími možnostmi by měl posoudit, u kterého nemocného je vhodné uvažovat o radikálním způsobu léčby a u kterého je případnější léčba konzervativní buď ambulantní, nebo nemocniční. Je plýtváním času i penězi podrobovat každého nemocného té či oné zobrazovací metodě, pokud je a priori jasné, že intervenční či chirurgická léčba je u něj z jakéhokoliv důvodu nevhodná. Jedině snad sonografie, která je nyní dostupná v řadě am-
bulantních pracovišť, může být na místě spíše z akademického zájmu zpřesnění diagnózy vyplývající z vyšetření klinického.
Je nutno si uvědomit, že lékař vyšetřuje celého člověka jako individuální organizmus a nikoliv pouze tepenný nebo žilní systém a musí vzít v potaz všechny dostupné údaje, které pomohou správně identifikovat chorobu jako takovou, i když se nejvíce projevuje právě v cévní soustavě. Neznamená to ovšem, že nevybíravě podrobíme nemocného široké paletě nejrůznějších vyšetření, ale existuje zkušenostmi verifikovaný rozsah základních poznatků, které bychom o každém nemocném měli vědět, jako je například tlak krevní, KO, základní biochemické vyšetření a podobně. Tyto vyšetřovací metody nejsou v této stati zahrnuty, protože jsou, nebo by měly být, standardními součástmi komplexní péče o tyto nemocné.
Anamnéza
I když nelze pokládat jednu součást klinického vyšetření za důležitější než druhou, je anamnéza pro výsledek vyšetření klíčová.
Bylo by hrubou chybou přizpůsobovat získané údaje počátečnímu diagnostickému dojmu, ale je nutno předpokládanou diagnózu přizpůsobovat nově získaným údajům, což pochopitelně platí i o následném vyšetření. Nicméně k určité racionální představě je možno se dopracovat.
Potíže mohou být v zásadě dvojího typu – akutní, nebo chronické.
Za akutní pokládáme ty, které vznikly náhle z plného zdraví, nebo kde dojde k náhlému výraznému zhoršení již existujících potíží. Samotný název naznačuje, že bez zbytečného váhání je nutno zhodnotit závažnost stavu z hlediska ohrožení orgánu či organizmu a neodkladnosti léčby. Zvláště je nutno vzít v úvahu, že pro rozhodnutí o akutnosti stavu není rozhodující, kdy nemocný vyhledal lékařské ošetření, ale charakter vzniku. Schopnost přehlížet i velmi těžké potíže je u některých nemocných překvapivá, i když vysoce nerozumná. Podrobněji budou rozebrány v příslušných statích, ale určitý obecný rámec napovídá následující tabulka (tab. 1.1), která bere v úvahu jen anamnestické údaje, nikoliv objektivní nález. Je ovšem značně zjednodušující, ale v zásadě pokrývá nejobvyklejší stesky nemocných. Vždy je však nezbytné nenechat se zaslepit i velmi barvitou anamnézou, ale je nutno konfrontovat ji s objektiv-
Tab. 1.1 Orientační diagnostická tabulka
Příznak Lokalita
Suspekní dg.Diferenciální dg.Poznámka
Silná bolest za sternem disekce hrudní AoIM hypertenze?
Silná bolest mezi lopatkamidisekce hrudní AoIM Marfanův syndrom?
Silná bolest bedra, třísla výduť břišní Aorenální kolikapohmat, angio*
Silná bolest břicho embolie visc. tepenNPB jiná anamnéza, angio*
Silná bolest končetiny embolie vertebro. anamnéza, tep
Zblednutí končetiny embolie uzávěr** tep, anamnéza
Chladnost končetiny embolie uzávěr** tep, anamnéza
Postižení senzitivních a motorických nervů končetiny embolie uzávěr** více než 6 hodin
Příznaky PIMrůzná stenóza ACI vertebro progrese? sono
Hemiparéza až hemiplegie končetiny uzávěr ACI intrakraniální krvácení sono, angio*
* pod pojmem „angio“ je míněno vhodné zobrazovací vyšetření ** embolie = náhlý uzávěr (uzávěr = na podkladě chronické stenózy)
ním nálezem. Pochopitelně je předkládána z hlediska cévního chirurga s vědomím, že to není diferenciální diagnostika v kostce, ale má jen upozornit na pravděpodobné akutní příhody, se kterými je žádoucí počítat.
Některé potíže zapříčiněné cévním onemocněním, alespoň v počátečním stadiu, se vyznačují prchavostí a nepravidelností vzniku. To platí zvláště o „přechodné ischemii mozkové“ (PIM) neboli „transient ischemic attack“ (TIA), kde různé sekundové parestezie či poruchy řeči vyšetřovaný opomene sdělit. Proto je nutné se konkrétně dotazovat na tyto a některé jiné obtíže.
Potíže chronické mohou být podobného charakteru, ale doba, po kterou trvají, je různá. Pro některé z nich je charakteristická trvalost, popř. pomalejší či rychlejší progrese. Typické jsou klaudikace dolních končetin. Při jejich hodnocení je žádoucí si uvědomit, že při delším trvání nemocný podvědomě přizpůsobuje životní styl svým obtížím, takže začne chodit pomaleji, vyhýbat se zvýšené námaze a podobně. Pro jiné potíže je zase typická přechodnost s kratšími či delšími intervaly. Takové jsou třeba parestezie buď obličejové, nebo končetin. Je také nutno mít na paměti, že současně mohou být postiženy různé oblasti cévního systému nebo i onemocnění jiného původu jiného orgánu, takže obtíže mohou být velmi různorodé a plastické. Obecně lze zařadit potíže zapříčiněné onemocněním tepen do několika skupin dle výskytu:
1. Končetiny dolní a) Klaudikace – potíže jsou charakterizovány jednoznačně křečovitou bolestí, většinou v lýtkových svalech, ale i ve svalech stehenních či hýžďových, v přímé souvislosti s činností, konkrétně chůzí, a to takové intenzity, že donutí nemocného k zastavení. Po určitém časovém intervalu bolest ustoupí a je možno pokračovat v chůzi a po jisté době se stav opakuje, zpravidla se zkrácením klaudikačního intervalu. V první řadě to závisí na tempu chůze či běhu a stupni vynaložené svalové námahy (schody, chůze do kopce). Ústup bolesti po zastavení je postupný, má určitou prodlevu. Pokud bolest ustoupí ihned, není způsobena nedostatečností tepenného zásobení. Pro objektivní hodnocení klaudikací byla vytvořena celá řada dotazníků (Roseho, San Diegův apod.), ale zvážení jejich skutečné závažnosti je stále v první řadě otázkou zkušenosti vyšetřujícího. Obecná shoda panuje v zařazení stupně potíží do určitých skupin podle různých autorů a u nás nejužívanější je zařazení dle Fontaina:
I. stupeň: nemocný nemá omezující obtíže a objektivní nález na tepnách je zjištěn náhodně při jiném vyšetření.
II. stupeň: nemocný má omezující klaudikace po určité vzdálenosti
A – po více než 100 metrech
B – do 100 metrů.
Chirurgická a intervenční léčba
III. stupeň: klidové bolesti – krevní oběh je nedostatečný i v klidu. Z počátku pomáhá svěšování končetiny, později jsou nutné stále stoupající dávky analgetik.
IV. stupeň: trofický(é) defekt(y) – je finálním stadiem, které ohrožuje organizmus a bez léčby jediným jeho vyústěním je buď ztráta končetiny, nebo smrt.
Toto rozdělení sleduje čistě praktické cíle, protože ve III. a IV. stadiu je končetina přímo ohrožena a indikační kritéria pro chirurgické či intervenční řešení se úměrně uvolňují.
b) Klaudikace hýžďové + erektivní impotence u mužů – klasický příznak Léricheova syndromu, to je uzávěru bifurkace břišní aorty.
c) Plantární klaudikace se pokládají za typické pro m. Winiwarter-Buerger, ale v netypické formě je mohou vyvolávat i onemocnění míšní a hematologická.
d) Pocity chladu akrálních částí – poměrně častý, ale nepříliš spolehlivý příznak uzávěru zvláště bércových tepen, častější u diabetiků. Diferenciálně diagnosticky přichází v úvahu zvláště Raynaudův syndrom, což opětovně může být prvním příznakem řady jiných onemocnění (krevní sklerodermie, kolagenózy atd.).
e) Parestezie, poruchy senzitivity a motoriky –častý stesk, který však bez předcházející fáze některého stupně klaudikací má obvykle necévní původ, stejně tak jako řada jiných, mnohdy velmi plasticky líčených potíží.
2. Končetiny horní
a) Raynaudova choroba – postihuje obvykle souměrně obě horní končetiny a její typické projevy jsou záchvatovitá zmrtvění, zblednutí a zchladnutí prstů, která jsou vystřídána cyanózou. Záchvaty jsou nejčastěji vyprovokovány chladem, ale i jinými příčinami, například psychickými. b) Bolesti – náhlé, trvalé, maximum na periferii; – zpravidla embolie do hlavních kmenů; – námahové – arteriosklerotický uzávěr – poměrně vzácný. Většinou postihuje odstup a. subclavia, eventuálně a. anonyma, kdy se projevuje jako subclavian steal syndrome, nebo střední úsek a. subclavia; – vasculitis různého typu – Tayasuova (nebo Takayasuova) choroba, obrovskobuněčná vasculitis, polyarteriitis nodosa apod.; – zevní útlak – Thoracic Outlet Syndrome (TOS).
3. CNS
Typické pro postižení tepen zásobujících mozek jsou příznaky přechodné ischemie mozkové charakterizované potížemi neurologického charakteru buď druhostranných končetin, nebo obličeje, polykání, řeči a jiné, ve velmi rozmanitých kombinacích. Vždy je nutno vyšetřit tyto tepny bez ohledu na to, s jakými cévními potížemi nemocný přichází.
4. Břicho
Příčiny tepenné u potíží nitrobřišních jsou nepoměrně méně časté, než ostatní klasická onemocnění, a proto podezření na tuto diagnózu se vyslovuje spíše per exclusionem. Zde se zaměříme na potíže chronické, nikoliv náhlé s podezřením na embolii.
a) Bolesti – v bedrech nebo břiše bez souvislosti s jídlem – nutno vyloučit výduť aorty; – v břiše v časové návaznosti na jídlo (angina abdominalis) – klíčovou roli hraje a. mesenterica superior a rozvoj kolaterálního oběhu mezi jednotlivými viscerálními tepnami. Jedná se zpravidla o aterosklerotický, pomalu postupující uzávěr, jen zřídka o zevní útlak, který je typický pro syndrom horní mezenterické tepny. Bolesti jsou křečovité, začínají asi půl hodiny po jídle a vrcholí za dvě hodiny po jídle. Nemocný se intuitivně brání vzniku bolesti menším příjmem potravy a kachektizuje; – v břiše v návaznosti na námahu dolních končetin – při uzávěru břišní aorty či pánevních tepen následkem odčerpání krve kolaterálami z a. mesenterica superior nebo inferior k femorální tepně.
b) Hypertenze – vždy nutno pamatovat na možnosti vztahu ke stenóze či uzávěru a. renalis.
Jedním z důležitých hledisek při hodnocení anamnézy jako celku je věk a pohlaví nemocného. U řady nemocných v jednotlivých skupinách je incidence té či oné choroby vysoce významná a do jisté míry diagnostické úvahy vyplývající z anamnézy zjednodušuje.
Pohled
Neobyčejně rozsáhlá skupina chorob se projevuje již na zevním vzhledu nemocného, a to od postavení
a chůze až po jednotlivé zevně postižitelné oblasti, jako je obličej, oči a podobně. V této stati se však budeme zabývat pouze hledisky, která mají vztah k onemocnění tepen.
Nemocného prohlížíme napřed ve stoje, a to zepředu i zezadu, a kromě postavení můžeme pozorovat otoky, barvu kůže a její rozdíly, například mezi horními a dolními končetinami, patologické útvary, žilní náplň a podobně. V leže se pak cíleně zaměřujeme na oblast, kde nemocný uvádí největší obtíže. Zde můžeme pozorovat:
a) Na končetinách – barvu kůže a hranice změny – bledost je typická pro tepenné postižení; – změnu barvy v závislosti na poloze; – ochlupení – ztráta ochlupení při postižení tepen;
– trofické změny – mohou být i žilního původu; – defekty – lokalita, charakter, rozsah; – vyklenutí – výduť a. fem. com., a. poplitea, AV malformace;
– stav svalstva – atrofie; – hybnost, zvláště akrálních oblastí; – stav povrchních žil; – přetrvávající otoky při horizontální poloze;
b) Na břiše – patologické vyklenutí, popřípadě pulzace;
– patologické žilní pleteně – kolaterální oběh;
c) Na hrudníku – konfiguraci; – dechové exkurze;
d) Na krku – patologické vyklenutí – střed – struma; – laterálně – tu glomus caroticum, výduť ACC; – náplň žil a její změnu při změně polohy.
Při tomto vizuálním hodnocení z hlediska cévního onemocnění zaznamenáme rovněž nápadné příznaky jiného charakteru, například exophthalmus, kožní onemocnění a podobně.
Pohmat
Při cévním vyšetření pohmatem můžeme zjistit:
1. Tep – přítomnost či nepřítomnost tepu na typických místech nám dává celkem jasnou představu o průchodnosti tepenného řečiště. Kvalitativní hodnocení je poměrně nepřesné a vyžaduje velkou zkušenost (například „tvrdý“ tep nad překážkou).
Je důležité, že při jakémkoliv vyšetření tepen je nutné kontrolovat tep na všech typických místech. Přístupné tomuto hodnocení jsou následující tepny (obr. 1.6): a. radialis, a. ulnaris, a. brachialis, a. axillaris, někdy a. subclavia, a. carotis commu-
Obr. 1.6 Typická místa pro pohmat O a poslech + tepen
nis, a. temporalis, u hubených osob břišní aorta, dále pak a. femoralis communis, a. poplitea, a. tibialis posterior a a. dorsalis pedis. Dále můžeme zjistit přítomnost tepu i na netypických místech, nejčastěji na dolních končetinách, ale také na penisu, zvláště pak v případě cévních malformací s arteriovenózním zkratem; – vír je hmatný v případech jednak arteriovenózního zkratu, jednak za těžkými stenózami při vysokém proudu s následnou turbulencí.
2. Teplotu kůže – jedná se o vyšetření orientační, kdy můžeme zaznamenat jednak rozdíly teploty mezi
končetinami, či na jedné končetině teplotní rozdíly mezi jednotlivými úrovněmi.V těchto případech se jedná o větší či menší chladnost. Naopak nad cévními malformacemi spojenými s AV zkratem zaznamenáme zvýšenou teplotu.
3. Patologické útvary – pod tento obecný výraz zahrnujeme hlavně vyklenující se výdutě, pravé či nepravé, a to obvykle v oblasti a. femoralis communis nebo a. poplitea. U nepříliš obézních pacientů jsou hmatné i v břiše, ale mohou být různého původu a popřípadě hmatný tep může být přenesený. Patologické útvary však mohou být kdekoliv, například výdutě poúrazové či tzv. falešné v průběhu cévní náhrady po předcházející rekonstrukci. Na horních končetinách jsou poměrně vzácné. Jsou charakterizovány pulzacemi, ale na krku přeneseně pulzuje i glomus tumor. Dalším pozorovatelným útvarem jsou různé typy vyklenujících se cévních anomálií, kde pulz může, ale nemusí být, záleží na tom, zda je spojen s AV zkratem.
4. Hybnost kloubů – zvláště pak periferních na dolní končetině, kde při déle trvající výrazné ischemii může být postižena hybnost zvláště malých kloubů.
Nelze opominout vyšetření per rectum, které, kromě zjištění hemoroidů jako součásti kolaterálního žilního řečiště, napomůže při diagnóze výdutí v oblasti vnitřních pánevních tepen nebo retroperitoneálního krvácení.
Poslech
Je nezbytnou součástí klinického vyšetření a odhalujeme jím šelesty. Ty jsou klasicky přítomné za stenózou, u výdutí a u AV zkratů. Za stenózou slyšíme systolický šelest různé intenzity, kdy do určitého stupně zúžení intenzita stoupá, ale při velmi těsné stenóze opětně klesá, protože průtok krve je příliš malý na vyvolání zvukového efektu. V kombinaci s kvalitou pulzu se dá stupeň stenózy poměrně dobře odhadnout. Propaguje se do různé vzdálenosti a sledováním v průběhu tepny nebo její hlavní větve do periferie lze stenózu také s jistou přesností lokalizovat. U výdutí záleží na velikosti a charakteru výdutě, jak se zvukově projevuje, ale zde se diagnóza nabízí již pohmatem. U arteriovenózních píštělí je šelest hrubý a většinou rozplizlý a sledovat jej můžeme hlavně po odvodné žíle. Vzhledem ke klinické závažnosti je pečlivý poslech zvláště důležitý v oblasti bifurkace a. carotis communis a na břiše u akutních stavů svědčících pro
symptomatické či prasklé aneuryzma aorty, kde hrubý šelest odhalí přítomnou aortokavální píštěl.
Při pečlivém klinickém vyšetření v uvedeném rozsahu lze u onemocnění tepen dospět k velmi přesné diagnóze a pokud z toho či onoho důvodu není radikální řešení indikováno, není žádné další vyšetření třeba. Pokud však toto řešení nevylučujeme, je nutné vyšetření doplnit zobrazovacími metodami, kde volíme tu nebo ty, které nám dodají patřičné informace nutné k odpovědnému rozhodnutí z hlediska indikačního, taktického i technického. V této souvislosti se nezabýváme postupy, které jsou využívány převážně angiology, jako je pletyzmografie, oscilometrie a podobně, protože jejich výsledky nemohou ovlivnit chirurgické či intervenční rozhodování. Na druhé straně jejich využití je plně na místě při sledování stavu po rekonstrukčních výkonech.
Diagnóza
U nejčastějších tepenných postižení je základní pracovní diagnóza poměrně velmi jednoduchá a postup pro její získání byl popsán. Nezanedbatelnou roli hraje i statistika výskytu jednotlivých onemocnění v rámci určité věkové, pohlavní, etnické a jiné skupiny.
Typické klaudikace jsou téměř neklamným příznakem uzávěrového onemocnění tepen zásobujících dolní končetiny, ať již jakéhokoliv původu. Musíme však přesně ohodnotit charakter obtíží a pokud typický průběh klaudikacím neodpovídá, je nutno uvážit i jiné příčiny, většinou vertebrogenního či neurologického rázu, ale bolestmi v končetinách se vyznačuje i celá řada jiných onemocnění jako je osteoporóza, tetanie různého původu a jiné. I když příznaky přechodné ischemie mozkové naznačují postižení tepen zásobujících mozek, nelze vyloučit ani škálu onemocnění jiných, čistě neurologických, od léze kory mozkové té či oné etiologie přes syndrom prodloužené míchy až po nádory.
Pro původ tepenný svědčí i známá skutečnost, že v řadě případů není toto postižení omezeno na jedinou oblast, ale současně je postiženo i jiné tepenné řečiště, takže nemocní trpí potížemi kardiálními, metabolickými, hypertenzí a jinými. Proto je zásadou odpovídajícím způsobem vyšetřit všechny tepenné oblasti a teprve při negativním nálezu je možno nemocného odkázat na jiné odborníky. Abychom se nedopustili jakéhokoliv zanedbání, je nutno vycházet z předpokladu, někdy ošidného, že nemocný nám
věrně reprodukuje své obtíže, a proto při negativním cévním nálezu doporučíme nemocného do další péče podle svého hodnocení možného diferenciálně diagnostického závěru.
Indikace
Pro další osud nemocného je indikace té či oné léčby klíčová a nelze dosti zdůraznit odpovědnost, která z toho pro lékaře vyplývá. Při pozitivním klinickém nálezu existuje řada možností:
1. Obtíže nemocného jsou minimální, nebo žádné. Záleží ovšem na postižené oblasti. Pokud se jedná o končetiny, je možno doporučit konzervativní postup a poučit nemocného o pravděpodobné prognóze. Pokud se však jedná o postižení tepen zásobujících mozek při jasném nálezu, objektivním nejsou stávající potíže primárně důležité, protože nekontrolovaný další průběh může vést ke katastrofě. Totéž platí pro orgány nitrobřišní či ledviny. Proto v těchto případech vždy uvažujeme o aktivním léčebném přístupu.
2. Při rozhodování o radikálním postupu je nutné, aby se na indikaci podílel chirurg, intervenční radiolog a anesteziolog a tito měli k dispozici všechna vyšetření nutná k odpovědnému rozhodnutí o optimálním řešení s nejmenším rizikem pro nemocného. V zásadě se přihlíží k potížím nemocného, stupni ohrožení orgánu či končetiny nebo organizmu jako celku, věku a celkovému biologickému stavu a pravděpodobné životní prognóze a únosnosti zátěže při tom či onom léčebném postupu. Z tohoto hlediska se zváží technické i taktické možnosti přístupu chirurgického či intervenčního. Jediné hledisko je prospěch nemocného.
3. V případě, že z nejrůznějšího důvodu je určitý postup kontraindikován, je nutno najít jiné řešení nejméně nebezpečné ze všech možných. Již dávno minuly doby, kdy si jak chirurgové, tak radiologové mysleli, že jejich možnosti jsou bez hranic a řada nemocných na to doplatila. Je nutno zvážit všechna možná rizika a v případě objektivně prakticky neřešitelné rekonstrukční situace je třeba při gangréně dolní končetiny doporučit přímo amputaci, než aby se k ní postižený dopracoval v krátké době řadou nepovedených rekonstrukcí ať chirurgických, či intervenčních.
4. Jiná je ovšem situace, kdy přímo hrozí smrt, jako třeba při prasklé výduti břišní aorty. V tomto případě nelze hovořit o riziku onemocnění, protože to představuje stoprocentní mortalitu, ale pouze
o procentu zachráněných. Různé skórovací systémy a zkušenosti pracoviště však vyloučí ze zbytečného výkonu případy zcela beznadějné.
5. Důležitá zásada platí tehdy, když kromě postižení tepenného povodí zásobujícího orgán působícím obtíže, s kterými nemocný přichází, je ještě zjištěn závažnější nález na tepnách zásobujících mozek, ať symptomatický nebo asymptomatický. V tomto případě je vhodné radikálně řešit tento nález jako první, protože jinak eventuálními změnami tlaku či hemokoagulace by nemocný byl přímo ohrožen iktem. Existuje ovšem řada případů, kdy je možný výkon simultánní (souběžný výkon na ACI a tepnách koronárních). Nicméně ve zcela obecné rovině by zásada primární preventivní rekonstrukce tepen zásobujících mozek měla platit též pro všechny závažnější výkony necévního charakteru, ale ne vždy je dodržována.
Při dnešní úrovni chirurgické, intervenční, anesteziologické a pooperační péče je vlastní indikace nejdůležitějším, ale současně nejslabším článkem léčebného postupu, a proto je nezbytné k ní přistupovat s maximální vážností, znalostí a odpovědností.
1.4.2 Zobrazovací metody
Duplexní sonografie
Každá správná stať o dopplerovském ultrazvuku by měla začít historií a velkými postavami dějin metody, obsahovat fyzikální principy a být plná obrázků, křivek a barevných mazanic.
Toto je ale publikace určená cévním chirurgům, a proto považujeme za nutné položit důraz poněkud jinam. Cévní chirurg se určitě musí orientovat v angiografických snímcích a CT obrazech, popř. hodnotit i MR-angiografie, nebude ale nikdy prohlížet a interpretovat obrazovou dokumentaci duplexního vyšetření (pokud je sám neprovádí a pak nemusí tuto kapitolu číst), protože v naprosté většině případů neexistuje a obrazy a křivky jsou jen na přechodnou dobu na obrazovce a v hlavě sonografisty, který z nich formuluje nález a diagnostický závěr. I když je možné udělat z vyšetření hardcopy (termopapír), videozáznam nebo digitální záznam paměťové smyčky, jedná se o silně subjektivně ovlivněný výstup s malou názorností i pro zasvěceného.
Co však cévní chirurg dělá? Odesílá pacienty na ultrazvuk, klade otázky, čte výsledný nález a konzultuje jej eventuálně se sonografistou. Ideální situa-
Chirurgická a intervenční léčba cévních onemocnění
ce je, když lékař na základě fyzikálního vyšetření a anamnézy může poslat nemocného z ambulance nebo oddělení rovnou (tedy bez objednávání) k ultrazvukovému vyšetření, výsledek má během krátké chvíle a může operativně rozhodnout o dalším osudu nemocného a dalších nutných vyšetřeních nebo léčbě. Pro nás sonografisty je to sice náročné, máme ale okamžitou zpětnou vazbu s aktuálním klinickým nálezem i klinikem samým.
Jako metoda jednoduchá, neinvazivní a levná stojí duplexní ultrazvuk na začátku diagnostiky před složitějšími a náročnějšími přístrojovými metodami jako jsou CT, magnetická rezonance nebo angiografie. Hovoříme-li o duplexním ultrazvuku, máme na mysli sofistikované přístroje minimálně s B-obrazem a dopplerem barevným, pulzním a energetickým. Tužkové dopplery, přístroje bez barevného mapování apod. jsou leda hračky pro malé děti. Kvalita přístroje má význam značný, kvalita vyšetřujícího ale zcela zásadní.
V žádném případě však sonografické vyšetření nenahrazuje fyzikální vyšetření. Požadavek typu „prosím o duplexní sono tepen a žil horních a dolních končetin“ svědčí o tom, že odesílající lékař cévám vůbec nerozumí, odebral anamnézu povrchně a nevyšetřil pacienta fyzikálně vůbec (na výtku reagoval dotyčný podrážděně: „Copak to nejde vyšetřit? Jde? Tak proč to tedy nevyšetříte?!“).
Vyšetřit duplexem lze opravdu skoro všechny cévy, orgány a tkáně v těle, ale toto vyšetření musí mít jasný cíl, odpovídat na srozumitelně formulovanou a konkrétní otázku a pak může pomoci v dalším rozhodování.
Nemá třeba smysl požadovat duplexní sonografii tepen dolní končetiny (i když toto pracné a časově náročné vyšetření je proveditelné). Naproti tomu zde dává smysl formulace třeba takových otázek: Je přítomna výduť na tepně? Je průchodná a. poplitea? Je stenóza na hluboké stehenní tepně? Je bypass průchodný? Jsou známky infekce protézy? Je příčinou otoku flebotrombóza? Jaký je vztah expanze k velkým cévám? apod.
Podrobné vyšetření tepen dolních končetin, na jehož základě lze odpovědně indikovat operativní nebo jiný postup, přinese jen angiografie nebo nověji některé podobné metody, jako CT- a MR-angiografie. Naopak zase duplexní ultrazvuk může upřesnit eventuální nejasnosti u těchto vyšetření, jsou-li nekvalitní nebo technicky suboptimální. Kalcifikace na karotických bifurkacích snižují hodnotu CT-angiografií. Stenty v iliackých tepnách znemožňují u MR-angiografie kvantifikaci restenózy v této lokalizaci, nedostatek projekcí skrývá změny v odstupu hluboké
stehenní tepny, venózní kontaminace znehodnocuje vyšetření periferie dolní končetiny. Těmto doplňujícím vyšetřením se nebráníme, naopak jsou jednou z důležitých indikací k dopplerovskému ultrazvuku. Z jednotlivých lokalizací je na prvním místě vyšetření větví aortálního oblouku (supraaortálních, precerebrálních). Jako screeningového vyšetření se používá u pacientů před velkými (v naší praxi před všemi) kardiovaskulárními operacemi, také jako screening u pacientů a jejich rodin s familiárními poruchami metabolizmu lipidů.
Jako diagnostické vyšetření se používá u nemocných s hemisferálními neurologickými symptomy (iktus, TIA, amaurosis fugax), šelesty nad větvemi oblouku, pulzující rezistencí v krční oblasti (možnost aneuryzmatu), k vyšetření nehemisferálních nebo nejasných neurologických symptomů. Sledujeme pacienty s prokázaným onemocněním karotid, kteří jsou zatím léčeni konzervativně a pacienty po operaci karotidy nebo endovaskulárních intervenčních výkonech, vyšetřujeme nemocné s podezřením na subklaviální steal syndrom, s příznaky vertebrobazilární insuficience apod.
Výsledný nález je kombinací změn v B-obraze (průběh a kalibr cév, vzhled a rozsah plátu, trombu), barevném spektru (absence signálu, směr toku, turbulence), pulzním dopplerovském záznamu (rychlost proudění, periferní odpor atd.) a dále dílem vzájemných vztahů mezi mozkovými tepnami, které díky propojení ve Willisově okruhu jsou vlastně svého druhu spojitými nádobami. Okořeněny zkušeností vyšetřujícího jsou nálezy vysoce spolehlivé a často se operuje na karotidách (nebo indikuje k endovaskulární intervenci) jen na základě duplexního vyšetření. V případě nejasností doporučujeme nejraději MR-angiografii, která netrpí artefakty z kalcifikací.
Stupeň postižení karotid nebo jiných precerebrálních tepen vyjadřujeme procenty stenózy (nebo spíše intervalem, ve kterém se postižení nachází), popř. slovně. První případ je jistě vhodnější, protože při slovním hodnocení mohou vzniknout nedorozumění (co si třeba kdo představuje pod pojmem „kritická stenóza“?). Bližší určení povahy ateromatózních lézí zvláště na vnitřních karotidách je z kvalitního B-obrazu možné a jistě vítané (rizikový vs. stabilní plát).
Transkraniální dopplerovská sonografie je cenným nástrojem pro posouzení vztahů ve Willisově kruhu a rezerv cerebrovaskulární perfuze, někdy se používá pro peroperační monitorování při karotické endarterektomii.
Na horních končetinách bývá požadavkem k vyšetření thoracic outlet syndrome, což je ale především
diagnóza klinická, sonografie může prokázat žilní trombózu, vzácně arteriální kompresi příslušnými manévry. Častěji je duplex využíván pro vyšetření dialyzačních píštělí.
Nitrohrudní cévy jsou vyšetřitelné transtorakálně jen velmi omezeně a zde je příležitost spíše pro echokardiografisty a jícnovou sonografii.
V subdiafragmatické oblasti často vyšetřujeme břišní aortu pro podezření na aneuryzma nebo kontrolujeme nemocné s dříve prokázanou dilatací abdominální aorty, nemocné po implantaci stentgraftů apod. Kromě velikosti výdutě vždy zmiňujeme vztah aneuryzmatu k renálním tepnám a eventuální spolupostižení iliackých tepen.
Vyšetření renálních tepen k vyloučení stenózy je poměrně obtížné a problematické zejména u obézních nebo meteorických nemocných, spolehlivějších výsledků dosáhneme CT- nebo MR-angiografií. Kromě aorty a jejích větví je samozřejmou součástí duplexního skenu vyšetření orgánů dutiny břišní.
Požadavky na vyšetření dalších viscerálních tepen a žil jsou relativně řídké, vyšetření však bývá celkem jednoduché, a jsou-li postiženy významně alespoň dvě ze tří splanchnických arterií (a. coeliaca, a. mesenterica superior et inferior), lze připustit, že pacient může mít abdominální angínu.
Transplantovaná ledvina se vyšetřuje vzhledem k poloze v kyčelní jámě dobře a kromě tepny štěpu se posuzují i intrarenální cévy, především s ohledem na eventuální rejekci, akutní tubulární nekrózu, trombózu žíly, přítomnost postbioptické falešné výdutě apod.
Speciální oblastí je duplexní vyšetření u transplantací jater, slinivky břišní aj.
Dopplerovský ultrazvuk je primární a v podstatě jediná zobrazovací metoda pro stanovení dysfunkce u TIPS (stenóza, okluze), problematika portální hypertenze je dnes ale cévní chirurgii vzdálena, stejně jako použití duplexní sonografie v onkologických aplikacích.
V oblasti pánve bývá položena otázka na stav tepen, ať již ve smyslu aneuryzmatické dilatace nebo obliterujícho postižení. Obraz a vyšetřitelnost mohou být limitovány obezitou, meteorizmem, bolestivostí. V třísle se setkáváme s komplikacemi invazivních vyšetření (pseudoaneuryzma, arteriovenózní píštěl) i infekcí. Penilní cévy jsou dobře vyšetřitelné, ale rekonstrukční chirurgie u erektilní dysfunkce je dnes zcela okrajová záležitost.
Infraingvinálně bývá předmětem vyšetření stav povrchní stehenní tepny, diagnostikujeme výdutě zákolenních tepen či sledujeme jejich eventuální progresi.
V popliteální oblasti řeší duplexní ultrazvuk diferenciální diagnostiku mezi aterosklerózou, entrapmentem, cystickou degenerací adventicie, degenerativním onemocněním kolenního kloubu apod.
Velmi často vyšetřujeme rozmanité tepenné rekonstrukce, počínaje supraaortálními cévami přes viscerální oblast a pak zejména v oblasti aortoiliacké a periferněji na dolních končetinách. Před dimisí každý pacient po rekonstrukci podstupuje ultrazvukové vyšetření, kdy hodnotíme eventuální rezidua po trombendarterektomiích, posuzujeme stav anastomóz bypassu, průběh protetického nebo žilního štěpu, kvantifikujeme průtok a posuzujeme periferní rezistenci, věnujeme pozornost i dárcovské tepně a tepnám pod rekonstrukcí a v neposlední řadě se zaměřujeme i na přítomnost komplikací, jako jsou trombózy, hematomy, seromy, abscesy, falešné výdutě aj. Stejné ukazatele hodnotíme při dalších kontrolách v pozdějším ambulantním sledování, především známky stenózujícího postižení při neointimální proliferaci, nepravé výdutě, infekce protézy, progresi aterosklerózy nad a pod rekonstrukcí atd.
Podobně vyšetřujeme i nemocné po endovaskulárních intervencích.
U žilního vyšetření se jedná buď o hluboké žíly končetin (obvykle otázka na flebotrombózu, popř. kontrolní vyšetření po proběhlé hluboké žilní trombóze), nebo povrchní vény (safénofemorální junkce, lokalizace insuficientních perforátorů před plánovanou operací nebo kvalita safény před odběrem pro rekonstrukční účely). Rekonstrukce žil vídáme ojediněle. Specifickou problematiku mají již zmíněné dialyzační zkraty, včetně protetických. U této skupiny nemocných také vídáme stenózy centrálních žil po opakovaných kanylacích.
Dopplerovský ultrazvuk může přispět i k diferenciální diagnostice mezi arteriovenózními malformacemi (vysokoprůtokový zkrat) a hemangiomy (žilní, kavernózní).
Intervenční dopplerovský ultrazvuk je nástrojem, který pomáhá při punkci velkých žil pod sonografickou kontrolou pro zavedení centrálního žilního katétru nebo pro přístup k intervenci (například zaměření pro punkci popliteální žíly při lokální trombolytické léčbě ileofemorální trombózy).
Pod navigací dopplerovským ultrazvukem provádíme perkutánní obliterace iatrogenních falešných výdutí v třísle i jinde. Pomáhá i při zaměření pro diagnostickou nebo léčebnou punkci kolekcí v těsné blízkosti cév nebo tepenných rekonstrukcí.
Pomocí ultrazvuku je možné označit na kůži místo, pod kterým je stenóza na žilní rekonstrukci nebo
Chirurgická a intervenční léčba cévních onemocnění
nepodvázaná větev safény u rekonstrukcí in-situ pro operativní reparaci.
Intravaskulární ultrazvuk (IVUS) nezaznamenal větší rozšíření, protože je v rutinní praxi limitován vysokými náklady a invazivností procedury.
Trojrozměrný (3D) ultrazvuk je další efektní metodou, ale rutinně málo používanou hlavně pro časovou náročnost a vysoké nároky na kvalitu přístroje.
Zavedení ultrazvukových kontrastních látek (známějších v echokardiografii) může rozšířit výtěžnost i dopplerovských vyšetření periferních cév, opět ale jen omezeně a přísně výběrově, především s ohledem na vysoké náklady na tyto substance.
CT-angiografie
Obecná část
Na začátku nového tisíciletí zaznamenává vývoj v oblasti výpočetní tomografie velký kvalitativní skok. Změny se týkají jak konstrukce tomografů, tak softwarového vybavení, i když princip zůstává zachován. Původní stroje byly vybaveny pouze jednou řadou detektorů zaznamenávajících záření procházející vyšetřovaným objektem. Nové přístroje mají od 4 do 64 řad detektorů, do výroby jsou však připravovány již stroje, které mají 128 řad. Spolu se ztenčením vrstvy pod jeden milimetr a rychlosti otáčky rentgenky v gantry pod 1 sekundu bylo dosaženo velmi rychlého sběru dat při spirálním vyšetření (rotace rentgenky probíhá zároveň s posunem stolu). Kvalita vyšetření je přitom vyšší a rovněž větší je rozsah vyšetření. Další nezanedbatelnou výhodou nových tomografů je optimální načasování startu vyšetření pomocí detekce obsahu kontrastní látky ve vyšetřované cévě, což umožňuje dosažení vysoké koncentrace kontrastní látky (nezbytný předpoklad dobrého výsledku), a to i u pacientů s nízkou srdeční ejekční frakcí. Díky výše popsaným změnám dochází ke zvýšení kvality obrazu konvenčního CT, zejména však skokově narůstá kvalita cévních rekonstrukcí a CT-angiografie nahrazuje podstatnou část indikací k diagnostickým vyšetřením, které byly předtím doménou DSA. Profit pacienta je též z méně zatěžujícího vyšetření – pouze intravenózní aplikace kontrastní látky, ambulantní výkon, krátká doba vyšetření.
S nástupem nové techniky se začínají pro označení tomografů používat termíny MSCT (Multi Slice Computer Tomography) nebo MDCT (Multi Detector Computer Tomography). Pro označení CT-angiografie se ustálila zkratka CTA.
Z nasbíraných dat během vyšetření se vytvářejí rekonstrukce, které jsou 3dimenzionální nebo 2dimenzionální. Do 3D rekonstrukcí patří VRT (Volume Rendering Technique), které jsou obvykle barevné, stínované a dávají celkový a efektní pohled na vyšetřované cévy. Zobrazují odlitkové cévní náplně. Problémem bývá sumace s kostěnými strukturami a s vápníkem ve stěně sklerotické cévy. Dříve používané 3D rekonstrukce typu SSD (Surface Shaded Display) ztratily na významu. Mezi 2D rekonstrukce patří MPR (Multi Planar Reconstruction), která umožňuje libovolným řezem vyšetřované tkáně (cévy) posoudit stěnu tepny a okolí. Obdobou této rekonstrukce je i MIP (Maximal Intensity Projection), která zvýrazňuje kontrastní cévní náplň při potlačení okolí. Obě tyto rekonstrukce jsou ve stupnici šedi.
Vlastní vyšetření je velmi podobné běžnému spirálnímu CT vyšetření, nutností je však aplikační pumpa, kterou se vstřikuje nitrožilně od 50 do 130 ml kontrastní látky rychlostí 3 – 5 ml/s.
Speciální část
Aortální CT-angiografie je metodou volby (spolu s MR v některých indikacích). Je přesná s velkým rozsahem (od aortálního oblouku po femorální tepny). Vyšetření je možné doplnit kalibrací cév při plánování další intervenční léčby (například implantace stentgraftů do aneuryzmatu). Při požadavku na zobrazení pouze ascendentní aorty se s výhodou používá EKG triggering, který odstraňuje pohybové artefakty pulzující aorty. Mnohem lepší informace než při DSA jsou získány u disekce – průkaz entry a reentry, trombóza falešného lumina, zasahování do aortálních větví, ischemie orgánů. U aneuryzmat je možné přesně stanovit trombózu vaku a změřit jeho velikost. U typických případů se lze vyjádřit i k etiologii (ateromatóza, zánět, trauma). Sledujeme rovněž eventuální krvácení z vaku. Mezi další patologie indikované k zobrazení patří koarktace, posuzuje se její významnost, lokalizace, kolaterální oběh a další anomálie (perzistence d. Botalli). Častým nálezem jsou variace tepen odstupující z aortálního oblouku nebo variace aorty samotné. Při pooperačních vyšetřeních se sledují anastomózy aortálních náhrad, disekce, pseudoaneuryzmata, okolí aorty (obr. 1.7).
CT-angiografie tepen aortálního oblouku a intrakraniálních tepen i pro tuto oblast při diagnostice plně nahradila klasickou angiografii. DSA tak zůstává jako metoda pouze pro ověření nejasných nálezů nebo jako součást intervenčního výkonu. Problémy při interpretaci nálezu nastávají u artefaktů způsobených
zubní výplní nebo náplní koncentrované kontrastní látky v žilách horní končetiny po aplikaci. Typickým výskytem zúžení nebo uzávěrů jsou odstupy tepen z oblouku a odstupy vnitřní a vnější karotické tepny (obr. 1.8). Neobejdeme se při posouzení významnosti zúžení bez MIP a MPR rekonstrukcí v tenkých vrstvách vzhledem ke kalcifikacím ve stěně. Při tomto způsobu rovněž lépe hodnotíme ulcerace a nástěnnou trombózu. Karotický sifon je hůře přehledný pro kostěné struktury v okolí. Intrakraniálně jsou již tepenná a žilní fáze společně. Dobře přehledný je Willisův okruh i drobné periferní tepny. Kvalitně se zobrazují variace tepen, aneuryzmata a nádory.
CT-angiografie renálních cév. Velmi často se zobrazují tepenná a žilní fáze najednou, žíla pak při svém ventrálním průběhu překrývá tepnu a je nutné zvolit nestandardní projekce pohledu (zadní pohled). Dobře hodnotitelné jsou jak kmenové tepny, tak tepny vyšších řádů, drobné periferní větve jsou však často překryty parenchymem nasyceným kontrastní látkou. U mladých pacientů je při fibromuskulární dysplazii zúžená tepna dobře hodnotitelná, problematické může být hodnocení drobných periferních tepen.
U aterosklerotických stenóz je nutné pro kalcifikace ve stěně provádět MPR a MIP rekonstrukce. Jednou z indikací jsou i mechanická (traumatická) poškození ledviny, zde přehledně zobrazujeme zkraty po biopsiích, pseudoaneuryzmata, subkapsulární hematomy, krvácení z lacerované ledviny. Dříve častá indikace
Obr. 1.7 VRT rekonstrukce aneuryzmatu abdominální aorty ošetřené stentgraftem. Dobrá funkce stentgraftu i jeho správná poloha.
k DSA – angiografie před nefrektomií u maligních nádorů je indikací k CTA též spíše ojedinělou a spíše se týká posouzení charakteru tumoru jako takového. Naopak často dnes vyšetřujeme příbuzenské dárce ledviny, kde angiografii provádíme k posouzení častých variací na tepenném (přespočetné tepny, atypický odstup) a žilním systému (počet žil, retroaortální průběh). Výkon doplníme vylučovací urografií k posouzení změn na dutém systému (obr. 1.9).
CT-angiografie splanchnických cév je ve všech indikacích, s výjimkou krvácení do GIT, metodou volby. Při podezření na abdominální angínu odhaluje stenózy velkých splanchnických tepen a dobře v 3D modelu zobrazuje kolaterální oběh (Riolanovu anastomózu). Hodnotí se aneuryzmata (často na lienální tepně) a pseudoaneurzmata (nejčastěji na horní mezenterické tepně ventrálně od slinivky břišní). Předoperačně (například resekce jaterních metastáz) se provádí anatomická studie odhalující časté variace. Součástí vyšetření tepen bývá i vyšetření žilního systému prováděné se zpožděním (asi 15 s) po arteriální fázi. Prokazuje průchodnost žilního systému, kolaterály při uzávěru magistrálních žil, variace. CT-portografie pak dává nejlepší obrazové výsledky a celkový přehled ze všech zobrazovacích metod (snad s výjimkou přímé portografie) (obr. 1.10). Totéž platí o jaterních žilách.
Končetinová CT-angiografie. Dolní končetiny bývají vyšetřovány v rozsahu od bifurkace aorty do
Obr. 1.8 MIP rekonstrukce významné ulcerované stenózy v odstupu a. carotis interna sinistra. Obrazové artefakty od zubních výplní.
Obr. 1.10 Aneuryzma v. portae a v. mesenterica superior. VRT rekonstrukce, odstranění okolních tkání editorem.
poloviny lýtek. Pokud je požadavek na zobrazení úplné periferie, je vhodnější provádět DSA. Toto platí zejména u diabetiků, kteří mívají výraznou mediokalcinózu znehodnocující výsledek a u kterých tyto tepny bývají nejčastěji postiženy. Jednoznačnou indikací jsou oboustranné uzávěry pánevních tepen nebo abdominální aorty, kdy není možný standardní přístup z třísla pro klasickou angiografii. Mimo uzávěry a stenózy jsou na tepnách dolních končetin ještě zobrazovány aneuryzmata (například vnitřní iliacké tepny), arteriovenózní zkraty v třísle po intervenčních výkonech. Obdobně jsou k vidění i arteriovenózní malformace. Bezproblémové jsou angiografie všech bypassů, které se dají hodnotit až na periferii nohy včetně zobrazení pedálních bypassů s transponovaným svalovým lalokem (obr. 1.11). Horní končetiny jsou k angiografiím indikovány méně, periferní tepny jsou obvykle naplněny méně než periferní tepny dolních končetin. Z pohledu stenóz a uzávěrů jsou nejdůležitější odstupy tepen z oblouku nebo místa krátce za odstupem.
CT-flebografie je srovnatelná s klasickou flebografií, dává však lepší informace o vedlejších anatomických strukturách a částečně též o vztahu k tepnám. Nevýhodou je horizontální vyšetřovací poloha. Naopak výhoda je v rychlosti vyšetření a malé množství aplikované ředěné kontrastní látky. Indikací k vyšetření dolních končetin jsou flebotrombózy, jiné trombózy hlubokého žilního systému, varixy , podezření
na Mayův-Thurnerův syndrom (stenóza levé společné pánevní žíly způsobená útlakem pravostrannou pánevní arterií v místě křížení) (obr. 1.12). Prováděny jsou i kontroly operačních a intervenčních zákroků na žilách. Na horních končetinách se flebografie provádí jako anatomická studie před založením dialyzačních shuntů a dále při průkazu TOS (Thoracic Outlet Syndrome).
CT-angiografie transplantovaných orgánů. Transplantovaná játra a ledvina jsou k CTA indikovány frekventněji než transplantovaná slinivka břišní. Nejčastějším problémem u transplantované ledviny i jater je stenóza v tepenné anastomóze. U jater je možné prokázat ještě stenózu v anastomóze portální žíly a dolní duté žíly (obr. 1.13).
MR-angiografie
K hlavním výhodám MR-angiografie patří úplná absence rizik spojených s expozicí ionizujícímu záření a minimalizace rizik spojených s event. podáním kontrastní látky. Pokud podáváme při MRA paramagnetickou kontrastní látku (viz dále), jedná se vždy o aplikaci do periferní žíly – jde tedy o miniinvazivní výkon, přičemž jeho další velmi významnou předností je prakticky zanedbatelná alergenicita a nefrotoxicita ve srovnání s jodovými kontrastními látkami používanými při CTA a DSA, která umožňuje
Obr. 1.9 VRT rekonstrukce zkratu mezi tepnou a žilou po ledvinné biopsii.